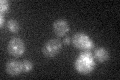
YLR360W

View description
Part of a Vps34p phosphatidylinositol 3-kinase complex that functions in carboxypeptidase Y (CPY) sorting; binds Vps30p and Vps34p to promote production of phosphatidylinositol 3-phosphate (PtdIns3P) which stimulates kinase activity
Localization:
Intensity:
Fold change:
Significance:
-
C’ GFP library in SD
punctate18.7 -
N' NOP1pr-GFP in SD

vacuole25.2051 -
N' TEF2pr-mCherry in SD

punctate10.6388 -
N' NATIVEpr-GFP in SD

punctate21.1997 -
N' TEF2pr-VC and Cyto-VN in SD

below threshold24.5199 -
C’ GFP library in SD+DTT

punctate19.791.05No -
C’ GFP library in SD+H2O2

punctate19.671.05No -
C’ GFP library in Starvation Media

punctate20.571.09No -
C’ GFP library on the background of Pup2-DaMP

punctate -
C’ GFP library on the background of CCT mutant

punctate18.81451.0059No
